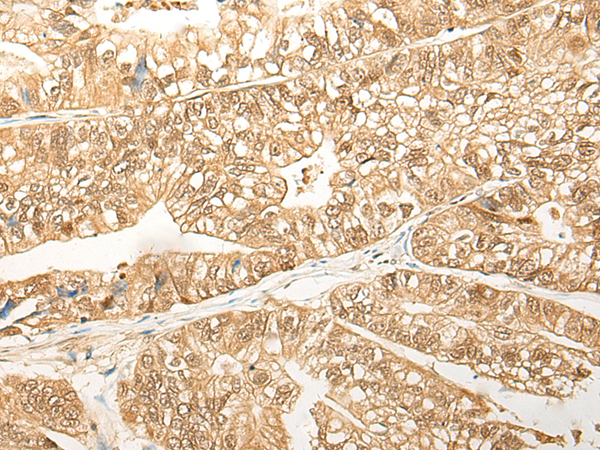
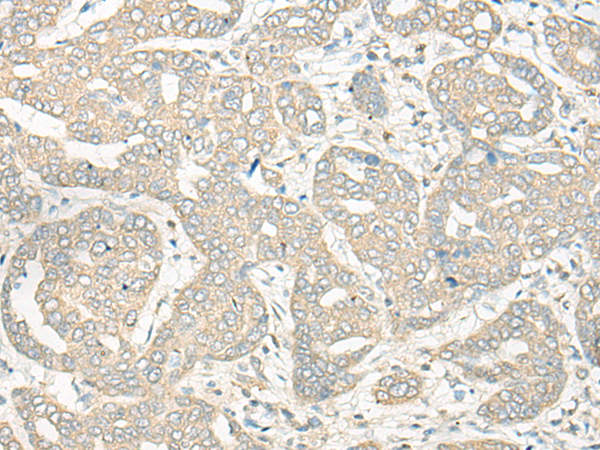

-
分类: 科研抗体货号: P09625别名: HN3; HsN3; PROS26; PROS-26应用: IHC反应种属: Human, Mouse, Rat
-
分类: 科研抗体货号: P09623别名: DFNA5; ICERE-1应用: IHC反应种属: Human
-
分类: 科研抗体货号: P09640别名: CNSA2; SH3P4; EEN-B1; SH3D2A应用: WB,IHC反应种属: Human, Mouse, Rat
-
分类: 科研抗体货号: P09622别名: PIF; AIDD; DSEP; HCAP; DCD-1应用: IHC反应种属: Human
-
分类: 科研抗体货号: P09628别名: FKSG15; IDDM21; TAGAP1; ARHGAP47应用: IHC反应种属: Human, Mouse
-
分类: 科研抗体货号: P09639别名: IMP; IMPA应用: WB,IHC反应种属: Human, Mouse, Rat
-
分类: 科研抗体货号: P09621别名: TRAMP应用: IHC反应种属: Human, Mouse
-
分类: 科研抗体货号: P09627别名:应用: IHC反应种属: Human
-
分类: 科研抗体货号: P09638别名: RSP-1应用: WB,IHC反应种属: Human, Mouse, Rat
-
分类: 科研抗体货号: P09620别名: RAB6IP1应用: IHC反应种属: Human, Mouse

鄂公网安备42018502007531号
鄂公网安备42018502007531号

